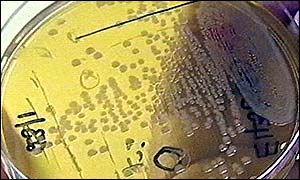
Petri dish

| You are in: Health | |||||||||||||||||||||||||||||||||||||||||||||||||||||||||||||||||||||||||||||||||||||||||||||||||||||||||||||||||||||||||||||||||||||||||||||
| Saturday, 27 July, 2002, 23:01 GMT 00:01 UK Viruses help make 'deadlier bacteria' Bacteria can be targeted by viruses Viruses which target bacteria could be helping produce deadlier strains - but also provide ways to tackle disease, say experts. These viruses, called bacteriophages, do not invade human cells - instead, they replicate in specific bacteria. However, their genetic manipulation of the host bacterium can leave it stronger than before.
This common microbe can cause a wide variety of illnesses, ranging from sore throats and scarlet fever to "flesh-eating" necrosis and toxic shock. The researchers focused on a particular strain - called M3 - which causes a particularly invasive infection and serious disease. They examined its genetic code to see what made it different from its less virulent streptococcus cousins. They found that 90% of its genes were shared with the other strep strains, but that the last 10% were unique to the highly-toxic M3. Looking more closely at these sections of genetic code, the scientists spotted telltale signs which linked them to bacteriophages. Swapping genes Viruses do not have any means of independent reproduction, as bacteria do. Instead they rely on harnessing the reproductive capacity of their host cell to make copies of themselves. During this process, it is possible that some of the bacteriophage's genetic code, perhaps some picked up from another organism, will be left behind in a surviving bacterial cell. In some cases, these new genes will change the way the bacterium functions. While often this will be to the disadvantage of the bacterium, occasionally the change will confer an advantage. Harnessing the power Evolution then takes over - a strain with such an advantage will prosper at the expense of other strains. Professor Mark Bailey, an expert in virology and microbiology from the Centre for Ecology and Hydrology at Oxford University, said that gene-swapping between bacteriophages and many different types of bacteria was common. He said that harnessing the power of bacteriophages could be key to future medicines. "The beauty of these viruses is that they are so specific - they target only one type of bacteria and nothing else," he said. "There is real potential to use bacteriophages in therapies in the future." | See also: 28 Sep 99 | Health 26 Sep 98 | Science/Nature 19 Nov 99 | Health Internet links: The BBC is not responsible for the content of external internet sites Top Health stories now: Links to more Health stories are at the foot of the page. | |||||||||||||||||||||||||||||||||||||||||||||||||||||||||||||||||||||||||||||||||||||||||||||||||||||||||||||||||||||||||||||||||||||||||||
Links to more Health stories |
 | ||
| ---------------------------------------------------------------------------------- To BBC Sport>> | To BBC Weather>> | To BBC World Service>> ---------------------------------------------------------------------------------- © MMIII | News Sources | Privacy |